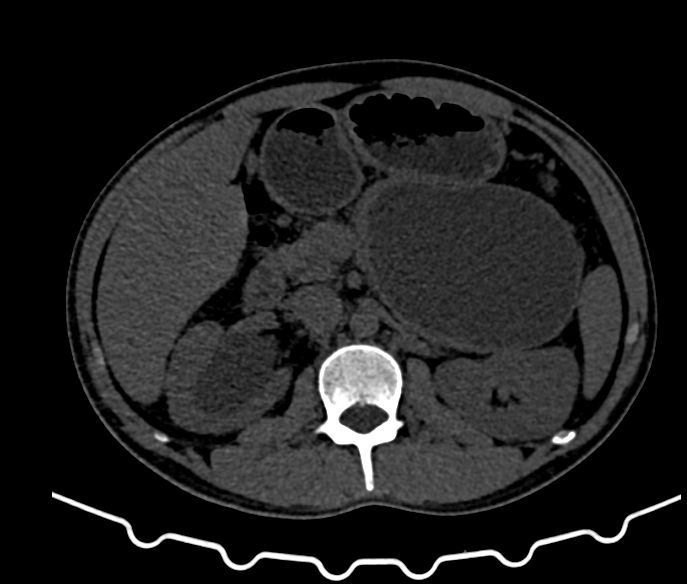

Patient Details:
- Age: 33-year-old male
- Complaint: Right flank pain
- Medical History: Previous history of pancreatitis

Findings:
Right Kidney:
- Size and Shape: Measures 11.4 x 5.1 cm; normal in size and shape.
- Condition: Markedly dilated right renal pelvicalyceal system with abrupt narrowing at the pelvi-ureteric junction. Cortical atrophy noted.
- Calculi: Multiple varying-sized calculi in the lower calyx; largest measures 15 x 9 mm (HU value 900-1050).
- Perinephric Fat: Mild stranding noted.
Left Kidney:
- Size and Shape: Measures 11.7 x 4.7 cm; normal in size and shape.
- Condition: No calculi, hydronephrosis, or contour deforming lesion.
- Perinephric Fat Planes: Clear.
Urinary Bladder:
- Condition: Adequately distended and normal.
- Other Findings: No evidence of calculi.
Prostate:
- Condition: Unremarkable.
Pancreatic Findings:
- Lesion: Well-defined rounded cystic hypoattenuating lesion, measuring approximately 11.3 x 8.3 x 7.8 cm (TRA x CC x AP).
- Location: Occupies the neck, body, and tail of the pancreas; inferior to the greater curvature of the stomach, anteroinferior to the spleen, and anterior to the upper pole of the left kidney.
- Impact: Abutting the greater curvature of the stomach and displacing the splenic vessels.
- Diagnosis: CT features suggestive of a pseudocyst of the pancreas.
Other Findings:
- Liver, Gallbladder, Spleen, and Adrenal Glands: Unremarkable.
- Bowel Loops: Unremarkable.
Impression:
- Right Pelvi-Ureteric Junction Obstruction: Moderate hydronephrosis and cortical thinning.
- Multiple Right Renal Calculi
- Large Pancreatic Pseudocyst

